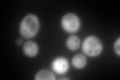
YCR053W
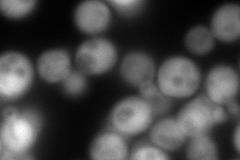
YCR053W
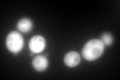
YCR053W
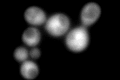
YCR053W
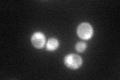
YCR053W

View description
Threonine synthase, conserved protein that catalyzes formation of threonine from 0-phosphohomoserine; expression is regulated by the GCN4-mediated general amino acid control pathway
Localization:
Intensity:
Fold change:
Significance:
-
C’ GFP library in SD
cytosol334.63 -
N' NOP1pr-GFP in SD

cytosol312.618 -
N' TEF2pr-mCherry in SD
cytosol393.808 -
N' NATIVEpr-GFP in SD

cytosol27.4536 -
N' TEF2pr-VC and Cyto-VN in SD

#N/A0 -
C’ GFP library in SD+DTT
cytosol405.631.21No -
C’ GFP library in SD+H2O2
cytosol317.780.94No -
C’ GFP library in Starvation Media
nucleusN/AN/AYes -
C’ GFP library on the background of Pup2-DaMP

cytosol -
C’ GFP library on the background of CCT mutant

cytosol352.5551.05353No
